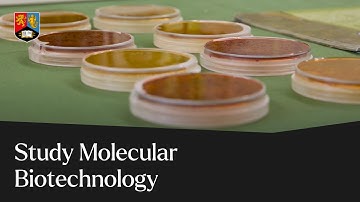
Why study Molecular Biotechnology | University of Birmingham

⬇ DOWNLOAD NOW
Kalau muncul iklan pop-up, tutup lalu klik tombol kembali
Download lagu Department of Molecular Biotechnology and Bioinformatics, PSUSci 2016 secara gratis hanya untuk keperluan promosi. Dukung artis favorit kamu dengan membeli musik original di iTunes atau platform resmi lainnya.
 Department of Molecular Biotechnology and Bioinformatics, PSUSci
Department of Molecular Biotechnology and Bioinformatics, PSUSci
 Biotechnology Undergraduate Programme at Molecular Biotechnology & Bioinformatics PSU (ENG subtitle)
Biotechnology Undergraduate Programme at Molecular Biotechnology & Bioinformatics PSU (ENG subtitle)
![[CUHK Science] B.Sc. in Molecular Biotechnology](https://i.ytimg.com/vi/e6ljpXO3NjE/hq720.jpg?sqp=-oaymwEjCOgCEMoBSFryq4qpAxUIARUAAAAAGAElAADIQj0AgKJDeAE=&rs=AOn4CLB0RWiqrEXpbzzh7sqippeu7JpPJw) [CUHK Science] B.Sc. in Molecular Biotechnology
[CUHK Science] B.Sc. in Molecular Biotechnology
 History and Events of Molecular Biotechnology || Biodotcom || #Shorts #Ytshorts
History and Events of Molecular Biotechnology || Biodotcom || #Shorts #Ytshorts
 Molecular Biotechnology
Molecular Biotechnology
 What Is Molecular Biotechnology? - Biology For Everyone
What Is Molecular Biotechnology? - Biology For Everyone
Why study Molecular Biotechnology | University of Birmingham
Why study Molecular Biotechnology | University of Birmingham
 A Look at the CSU Channel Islands Masters of Science in Biotechnology and Bioinformatics Program
A Look at the CSU Channel Islands Masters of Science in Biotechnology and Bioinformatics Program